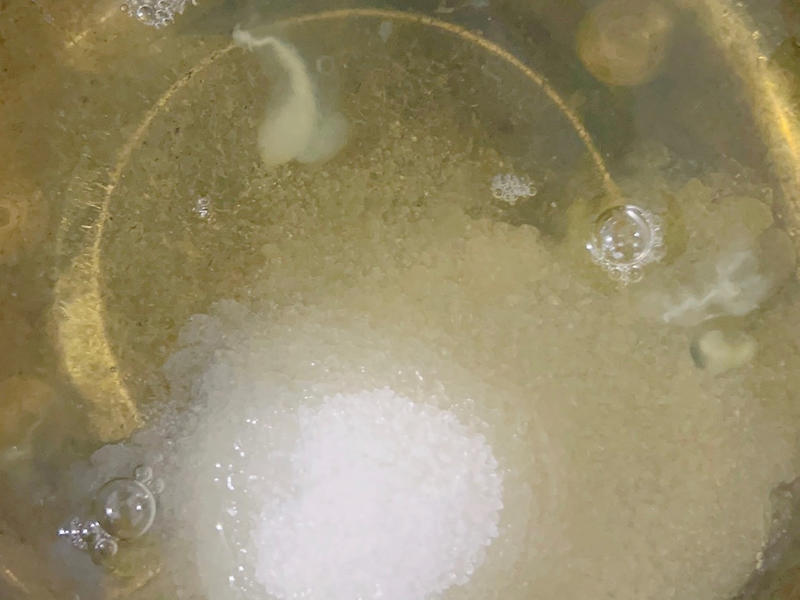
纯奶手撕吐司的做法 步骤1

用APP打开 

牛奶和玉米油混合乳化

然后加入低筋面粉混合均匀

鸡蛋的蛋黄与蛋清分离.蛋黄打入刚刚的面糊里,然后翻拌均匀.
这里可以先预热烤箱上下140度左右。 蛋清单独放入在一个无水无油的盘里.然后倒入45克细砂糖和几滴柠檬汁或白醋去腥.然后打发到稍微偏一点点硬的状态.

大概是这样,软中偏硬的状态即可。

打发好的蛋白分3次加入到面糊里搅拌均匀.

28*28的烤盘里铺上油纸,上下140度烤25分钟.然后调到160度烤3-5分钟,这时候注意别离开烤箱,随时观察表面上色情况。

180克的蓝风车淡奶油加入15的细砂糖打发到偏硬的状态。

均匀的抹在晾凉的蛋糕卷上。然后卷起来后放入冰箱冷冻定型半个小时。然后在切块。

好吃的蛋糕卷就完成啦~

软软的蛋糕体配上香香的奶油~














